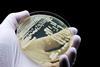
Hand,Of,Doctor,Or,Scientist,Showing,A,Microbiological,Culture,Of

All Article articles
View all stories of the same content type.
-
Article
Beyond the hype: a veteran's honest assessment of AI in drug discovery
An interview with Thibault Géoui reveals why this technology wave might finally break through pharma’s productivity crisis – and why it will take longer than the optimists claim.
-
 Article
ArticleAnticipating adaptation: understanding and overcoming cancer drug resistance
Neil Bhowmick explores how understanding the mechanisms of cancer drug resistance has reframed our approach to treatment, revealing containment and control as realistic goals for therapeutic strategies.
-
 Article
ArticleKMA and LMA antigens emerge as high value targets for plasma cell dyscrasia treatment
Research published in Clinical Lymphoma, Myeloma and Leukemia identifies Kappa Myeloma Antigen and Lambda Myeloma Antigen as highly selective immunotherapy targets across plasma cell dyscrasias.
-
 Article
ArticleWhy NMDA receptor modulation remains central to next-generation depression therapies
A key player in brain communication and mood regulation, the pharmaceutical industry views the NMDAR as the central pillar for next-generation therapies for depression. Dirk Beher from FundaMental Pharma reveals new strategies for targeting this important receptor.
-
 Article
ArticleDesigning targeted assays for clinical success from the start
Why do some targeted assays move smoothly from discovery to clinical practice while others stall? The answer often lies in the earliest design decisions, where choices about samples, platforms and data determine what is possible later.
-
 Article
ArticleDiscovery is changing – and automation leads the way
Automation is helping drug discovery teams screen faster, cut costs and run complex assays at scale – but its real value lies in what happens next.
-
 Article
ArticleNavigating IND delays: strategic options for early-phase biotech development
As IND timelines lengthen, early-stage biotechs face growing uncertainty in early clinical planning. This article explores how sponsors are increasingly diversifying their development strategies and why New Zealand represents an attractive option.
-
 Article
ArticleWorld ADC 2026: where antibody-drug conjugates are heading
At World ADC London 2026, experts highlighted how advances in payload design, targeting strategies and AI-driven discovery are changing antibody–drug conjugate development.
-
 Article
ArticleInternational Women’s Day: digital pathology in early drug discovery
For International Women’s Day, Dr Amanda Hemmerich, Global Director of Digital Pathology & Innovation at IQVIA Laboratories, describes how digital pathology is being applied in early drug development and what it takes to build credibility in a multidisciplinary technical field.
-
 Article
ArticleHow brain donation is driving autism research
To study the biological underpinnings of autism, researchers must examine the human brain itself. This article explores how Autism BrainNet supports this work through coordinated tissue donation and preservation.
-
 Article
ArticleWhy most labs are not ready for AI: Cenevo shares what must change
Most labs want to use AI, but few have the digital foundations to support it. Cenevo’s leaders explain why progress is slow and what laboratories must fix before AI can deliver real value.
-
 Article
ArticlePreclinical takeaways from the World ADC Conference London
Experts from the World ADC Conference in London highlight how patient-centric, predictive preclinical tools and innovative ADC designs are improving safety, efficacy and clinical translation.
-
 Article
ArticleDrug discovery integration takes centre stage at SLAS Boston 2026
Drug discovery has no shortage of powerful technologies, but the challenge now is making them work together. At SLAS Boston 2026, researchers and technology developers revealed how laboratories are connecting the entire experimental pipeline.
-
 Article
ArticleMaking immunotherapy safer and more accessible through continuous digital monitoring
Immunotherapies such as CAR-T are extending survival, yet reliance on inpatient monitoring for cytokine release syndrome continues to restrict access. This article explores how continuous digital monitoring and AI-driven analysis could enable safer outpatient delivery and support more scalable immunotherapy adoption.
-
Article
ArticleIntegrated proteo-transcriptomics reveals multiple therapeutic targets in Candida auris
Scientists at the Medical University of Vienna identify multiple mechanisms of multidrug resistance in Candida auris, revealing new therapeutic opportunities.
-
 Article
ArticleAdvancing drug discovery with reproducible, animal-free 3D systems
Lukas Gaats and his team at mo:re are using automation to bring consistency to 3D cell culture and move drug discovery beyond animal models. Read on to find out how.
-
 Article
ArticleThe map and compass: integrating BD&L early to de-risk drug discovery
In drug discovery, great science alone is not enough because commercial viability ultimately decides which programmes survive and attract partners. This Q&A explores how integrating Business Development and Licensing (BD&L) from the earliest stages can guide R&D strategy, sharpen decisions and de-risk the path to market.
-
 Article
ArticleReplacing animals in science: what the UK’s new strategy means
The UK has set out a strategy to replace animal testing, but delivering change will depend as much on regulation as on technology. Dr Emma Grange, Director of Science and Regulatory Affairs at Cruelty Free International, examines what the policy signals for research, drug discovery and safety assessment.
-
 Article
ArticleVibe coding 101 for drug discovery scientists
Find out how AI-assisted development is democratising software creation in life sciences.
-
 Article
ArticleEngineering the next generation of T-cell engagers
T-cell engagers are a branch of immunotherapy that has undergone considerable change since their clinical inception. Andrew J Souers, VP, Oncology Discovery Research at AbbVie, elucidates the current understanding of their biology and expanding focus areas of application.



